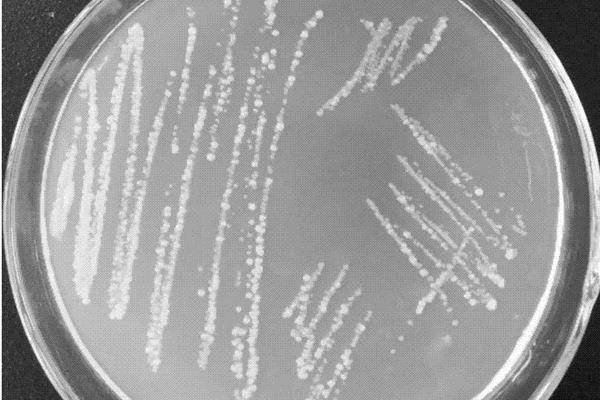
甘油菌菌种活化步骤，甘油菌怎么保存

甘油菌菌种活化步骤,甘油菌怎么保存

1、LB培养基制备:准备10g胰蛋白胨,5g酵母提取物,10g氯化钠,加入800ml去离子水,拌匀,直至完全溶解,然后用0.2ml氢氧化钠(5mol/L)将ph调节到7.4,并加入1L去离子水,高压蒸汽灭菌。2、倒平板:培养基放置在60℃水浴锅中保温,取出后,轻轻转动培养基,让琼脂分布均匀。
一、甘油菌菌种活化步骤
1、LB培养基制备
(1)准备10g胰蛋白胨,5g酵母提取物,10g氯化钠,然后加入800ml去离子水,搅拌均匀,直至完全溶解,接着使用0.2ml的氢氧化钠(5mol/L)将ph调节到7.4左右,并加入1L的去离子水,高压蒸汽灭菌20分钟左右。
(2)在高压灭菌之前,应当加入15g/L(铺制平板用)或7g/L(配制顶层琼脂糖用)的琼脂糖。

2、倒平板
(1)超净台、接种环、培养皿,酒精灯等用紫外线灭菌30分钟左右。
(2)高压灭菌后的培养基放置在60℃的水浴锅中保温,等到溶液尚未冷却的时候,将培养基取出,轻轻转动,让琼脂均匀分布在培养基溶液中。
(3)等到冷却至50℃的时候,在超净台中加入抗生素,并旋转将培养基混合均匀,然后从烧瓶中倾出培养基铺制平板。
(4)将甘油菌冻存管放在冰上,直接用接种环在冻存管内的冰渣上蘸一下,然后涂上平板。
3、大量培养
(1)将冷藏的液态培养基重新高温高压灭菌,等到冷却至50℃的时候,加入抗生素,接着将菌落挑至已经加入抗生素的液态培养基中(2-5ml),37℃,200rpm培养8小时左右。
(2)按照1:500-1000的比例,将添加了抗生素的液态LB培养基稀释上一步骤所得菌液(20-25μL菌液+25ml液态LB培养基),37℃,200rpm培养12-16小时。

二、甘油菌怎么保存
1、如果是20%甘油保存菌种(甘油:菌液=20:80),一般放置在零下70℃的环境下保藏。
2、如果是一般细菌的菌种,在纯化后,接种在普通肉汤管中,然后经过4-6小时增菌后,放入适量甘油-生理盐水保存液,在零下20℃的环境下进行保藏。如果是链球菌属和奈瑟氏菌属的菌种,在纯化后,接种在血清肉汤管中,在5-10%CO2中经过8-10小时增菌后,加入适量甘油-生理盐水保存液,放置在零下80℃的环境下进行保藏。如果是真菌菌种,在纯化后,直接取菌洗入肉汤,加入甘油-生理盐水保存液,放置在零下20℃的环境下进行保藏。
- 问苹果褐斑病特效药褐斑病发病初期可用80%多菌灵可湿性粉剂1000-1200倍液、77%硫酸铜钙可湿性粉剂600-800倍液,每隔10-20天,连续喷3-5次。出现大量病斑时可用50%多菌灵可湿性粉剂800-1000倍液、50%异菌脲可湿性粉剂1000-1500倍液、70%甲基硫菌灵可湿性粉剂800-1000倍液。
- 问西红柿未成熟就腐烂是啥原因,要怎么防治西红柿未成熟就腐烂是番茄脐腐病,是一种生理性病害,原因是水分的供应失调缺钙等。一般在果实长至核桃大时发生,最初表现是西红柿脐部出现水浸状病斑,表面会有白色、黑色及粉红色的霉菌。当叶片消耗了大量的水分后,就导致了脐部的水被叶片吸收,果实内部水分出现失调,生长发育受到阻碍,形成脐腐。
- 问羊奶果适合什么地方种植羊奶果适合在广东、广西、云南、江苏等地方种植。羊奶果适合生长在光照充足、雨热条件良好的地方,若生长环境高温高湿,则长势会更好。羊奶果可采用播种、扦插或嫁接的方式进行繁殖,无论使用哪种方法都要等到小苗的高度达到5厘米左右才能移栽。
- 问山地丘陵区一般不宜种植需要耕作的作物,山地丘陵区的自然特点是什么山地丘陵区一般不宜种植需要耕作的作物,它们更适宜发展林业或牧业。山地丘陵区之所以不宜种植需要耕作的作物,是因为它具有土层薄、土壤粗骨性的特点,不仅会限制植物的扎根,而且土壤贮藏水肥的容量也降低了。
三农问答









